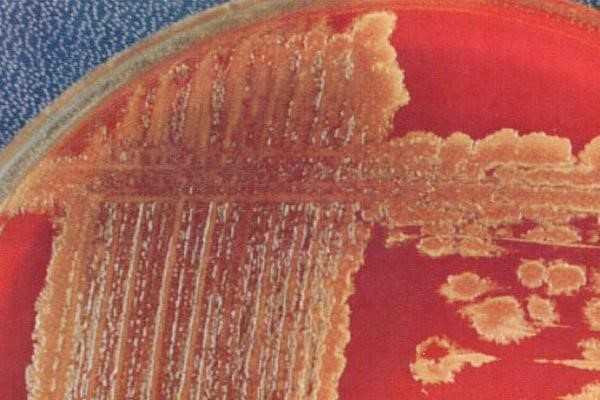
Стрептококки 1

Стрептококковые инфекции вызванные Streptococcus pyogenes: диагностика, лечение, профилактика
Добавил пользователь Владимир З. Обновлено: 22.11.2025
В этой статье мы поговорим о более сложных темах на примерах тех представителей микробного мира, которые в большинстве случаев являются нашими добрыми соседями и очень редко, при очень специфических условиях, вызывают заболевания. Но так как лаборатории, особенно оснащенные автоматизированными системами детекции, все это определяют и буквально вываливают на врачей, ориентироваться и в этом море информации все-таки необходимо.
Материалы предназначены исключительно для врачей и специалистов с высшим медицинским образованием. Статьи носят информационно-образовательный характер. Самолечение и самодиагностика крайне опасны для здоровья. Автор статей не дает медицинских консультаций: клинический фармаколог — это врач только и исключительно для врачей.
Автор: Трубачева Е.С., врач - клинический фармаколог
Почему за исключением S. pyogenes? Да потому что данного возбудителя мы рассмотрели в отдельной статье. Кроме того, мы уже говорим практически на одном языке, а потому можем себе позволить поговорить о более сложных темах на примерах тех представителей микробного мира, которые в большинстве случаев являются нашими добрыми соседями и очень редко, при очень специфических условиях, вызывают заболевания. Но так как лаборатории, особенно оснащенные автоматизированными системами детекции, все это определяют и буквально вываливают на врачей, ориентироваться и в этом море информации все-таки необходимо.
Микробиологические аспекты
Для начала разберемся с классификациями, чтобы понимать принципы разнесения стрептококков по группам. Так сложилось, что для классификации стрептококков используются их фенотипические характеристики, а именно характеристики по гемолитическим свойствам:
- β-гемолитические стрептококки вызывают полный гемолиз эритроцитов питательной среды с формированием прозрачной зоны вокруг колоний на кровяном агаре
- α-гемолитические (зеленящие) образуют зеленоватый ореол вокруг колоний в результате неполного разложения гемоглобина

- γ-гемолитические по-другому именуются негемолитическими, то есть ничего никуда из крови не разлагают.
Собственно, почему кровь? Дело в том, что стрептококки крайне требовательны к питательным средам и к условиям, в которых их растят. И чтобы они выросли, в питательные среды (в основном, жидкие) необходимо или добавлять мясной экстракт, или использовать коммерческие питательные среды с добавлением крови барана, или 5%-й кровяной агар - и все это с большим количеством дополнительных компонентов. Для определения характера гемолиза традиционно используется среда с 5%-й дефибринированной кровью барана.
Подобное разделение по группам и типам гемолиза является решающим для деления стрептококков, имеющих медицинское значение, позволяя разделить патогенные и условно-патогенные микроорганизмы. Про патогенные мы уже поговорили ранее, теперь будем вести разговор о более обширной группе условно-патогенных представителей и начнем со стрептококков групп A, C, D и F, оставив для отдельного разговора группу В и единственного ее представителя - S. agalactiae.
Основными характеристиками представителей этих групп является то, что все они:
- Обладают β-гемолитической активностью
- Относятся к нормальной микрофлоре человека и животных
- Могут вызывать оппортунистические инфекции в различных локализациях
Еще одним общим, и, что главное, клинически значимым свойством является то, что стрептококки могут вырабатывать внеклеточные вещества, которые обладают антигенной активностью и играют важную роль в развитии стрептококковых инфекций. Подробнее с характеристикой таких веществ можно ознакомиться в книге «Иммунология» А. Ройта (так как там все описано чрезвычайно просто и наглядно, чего никак не хватает нашим авторам), здесь же мы кратко укажем основных из них:
- Fc-антиген, способный взаимодействовать с Fc-фрагментом IgG, тем самым угнетая систему комплемента и подавляя активность фагоцитов. Кроме того, он же активирует выработку аутоиммунных антител, которые в дальнейшем участвуют в развитии иммунного воспаления;
- Р-антиген, обладающий иммуносупрессивной активностью и являющийся общим для всех стрептококков. Он подавляет выработку антител и усиливает реакции гиперчувствительности замедленного типа.
Кроме того, стрептококки имеют такой фактор патогенности, как М-протеин, который нарушает фагоцитарную активность путем маскировки рецепторов для комплемента, что очень затрудняет борьбу с этими возбудителями.
Клинические аспекты
1. Streptococcus dysgalactiae - объединяет двух представителей Streptococcus dysgalactiae subsp. dysgalactiae и Streptococcus dysgalactiae subsp. equisimilis. Первый живет на животных (и вызывает маститы у коров, на человеке в качестве возбудителя пока не ловили), второй на человеке - в верхних дыхательных путях и влагалище - и может быть причиной менингита, септических артритов и инфекций кожи (при условии наличия соответствующей симптоматики и в отсутствии других вероятных возбудителей).
2. Стрептококки группы Anginosus (S. anginosus, S. constellatus, S. intermedius) относятся к представителям нормальной флоры человека. Обрести зубы и стать возбудителями инфекции их могут заставить травмы, оперативные вмешательства, сахарный диабет, онкологические заболевания и иммунодефициты различной этиологии. Сами по себе на человека не бросаются и обнаружение оных вне клинической картины истребления не требует.
- S.anginosus - в норме обитает в полости рта, верхних дыхательных путях и влагалище. При патологии может быть высеян из урогенитальной и желудочно-кишечной локализаций.
- S. constellatus - в норме живет в верхних дыхательных путях и ЖКТ. При патологических процессах могут быть обнаружены где угодно.
- S. intermedius - в норме обитает в полости рта и верхних дыхательных путях. При патологических процессах в основном высевается из мозга, из крови при эндокардитах и из печеночных абсцессов (проще говоря оттуда, где в норме все должно быть стерильно).
3. S. equi клинического значения не имеет, так как является зоонозом и вызывает ветеринарные проблемы у коров, лошадей, морских свинок, овец и коз. Иногда - при употреблении зараженных молочных продуктов - может быть обнаружен у людей, больных нефритом.
4. S. canis, как понятно из названия, выделяют от собак. У людей могут вызывать инфекции мягких тканей, пневмонии, сепсис, остеомиелит.
5. S. iniae - обнаруживается у дельфинов и рыб. А также у людей, занятых на обработке замороженной рыбы. Крайне редко вызывает заболевание (описаны всего несколько случаев), хорошо лечится бета-лактамами и макролидами.
6. И несколько чисто зоонозных представителей, не имеющих медицинского значения, но иногда сеющихся с людей, которые за этими животными ухаживают или лечат:
- S. porcinus - вызывает абсцессы глотки свиней, пневмонию и аборты;
- S. didelphis - вызывает инфекции кожи, печени, легких и селезенки у опоссумов;
- S. phocae - выделяется у морских котиков при пневмонии у оных.
Как мы увидели, в большинстве своем перечисленные возбудители относятся к нормальной микрофлоре верхних дыхательных путей, кожи, ЖКТ и урогенитального тракта, а чтобы они вызвали заболевание, во внутреннюю среду организма должно проникнуть очень большое количество оных, при этом иммунная система должна быть подавлена тем или иным образом. Чаще всего такую роль играют медицинские вмешательства (инъекции, операции, катетеризация сосудов, гемодиализ и т. п.) на фоне тяжелых основных или сопутствующих заболеваний. Тогда стрептококки способны вызвать инфекции кожи и мягких тканей, верхних дыхательных путей, эндокардиты и сепсис, инфекции урогенитального тракта, при этом строгой локализации процесса соответствующим возбудителем уже не будет, а будет инфекция, связанная с медицинским вмешательством.
Что делать?
Как можно раньше провести бактериологическую диагностику и главным в ней будет правильная техника взятия биологического материала, чтобы точно исключить его контаминацию ни в чем не повинными мирными соседями, просмотрев истинного возбудителя. Техника взятия материала и правила транспортировки в лабораторию подробно расписаны здесь.
Чем лечить?
Этот вопрос мы можем задать только тогда, когда точно понимаем, что именно вышеуказанные зверушки являются возбудителями и никто за ними не прячется. Хорошая новость в том, что стрептококки до сих пор сохранили высокую чувствительность к бета-лактамам вообще и к пенициллинам в частности, то есть лечить их дешево. Плохая новость в том, что фактически утеряна чувствительность к макролидам, и поэтому они не могут быть препаратами выбора - это обязательно надо учитывать при назначении стартовой терапии.
Кроме того, стрептококки продолжают демонстрировать высокую чувствительность к ванкомицину, но в виду неоднозначности самого препарата в плане безопасности его применения, им тоже не следует злоупотреблять и включать его в схему лечения только в случае наличия аллергии к пенициллиновому ряду.
Итак, мы закончили краткое рассмотрение представителей стрептококков групп A, C, D, F и G, и нам осталось рассмотреть только одного представителя из группы В, а именно S.agalactiae, чем мы и займемся в следующей статье.
Стрептококковые инфекции
Стрептококковые инфекции - группа заболеваний, вызываемых стрептококками разных видов. Проявляются преимущественным поражением дыхательных путей, кожи и подкожной клетчатки, мочеполовой системы. Естественная восприимчивость человека к стрептококковым микроорганизмам высокая, поэтому инфекции данной группы широко распространены во многих странах мира. Наиболее восприимчивы к стрептококку дети и люди с ослабленным иммунитетом. Всплески заболеваемости отмечаются в холодное время года.
Содержание
Классификация
В основе классификации стрептококковых инфекций лежат тип возбудителя, клинические проявления, тяжесть воспалительного процесса, характер и продолжительность болезни. Формы заболеваний, вызываемых стрептококками, а также их характеристика представлены в таблице.
Обратите внимание! Гемолитические стрептококки группы B - одна из частых причин гнойно-септических осложнений у женщин в послеродовом периоде, а также тяжелых состояний у новорожденных.
Причины стрептококковых инфекций
Инфекция вызывается бактериями рода Streptococcus. Стрептококки устойчивы в окружающей среде, сохраняются в высушенных биоматериалах (мокроте, гное) в течение нескольких месяцев. Погибают при воздействии высоких температур и дезинфицирующих растворов. Резервуаром и источником инфекции выступают носители бактерий или больные люди. Заболевание передается разными путями:
воздушно-капельным - при разговоре, кашле или чихании;
пищевым - при употреблении зараженных продуктов;
контактным - через грязные руки;
половым - при половых контактах;
вертикальным - от матери ребенку.
После перенесенного заболевания формируется устойчивый иммунитет, однако это не исключает повторного заражения стрептококками другого вида.
Патогенез
Симптомы стрептококковой инфекции
Клиническая картина заболевания очень разнообразна по причине большого количества возможных локализаций очага инфекции . Симптомы болезни зависят также от общего состояния организма и типа стрептококка. Так, гемолитический стрептококк группы A чаще поражает дыхательные пути, слуховой аппарат, кожу, приводит к развитию скарлатины и рожистого воспаления, а стрептококки группы B вызывают воспаление органов мочеполовой системы, часто становятся причиной послеродовых инфекций. В зависимости от пути заражения стрептококковая инфекция может проявляться в виде ангины, стрептодермии или уретрита.
Ангина
сильную боль в горле;
иногда головные боли.
Боль в горле может появиться одновременно с подъемом температуры тела или на следующий день. При осмотре наблюдается сильное увеличение миндалин, покрытых белым налетом, обнаруживается увеличение шейных лимфатических узлов. Характерной особенностью стрептококковой ангины является отсутствие насморка и кашля, которые часто сопровождают вирусные инфекции .
В большинстве случаев острый период длится не более 7-10 дней. Заболевание заканчивается полным выздоровлением, при отсутствии лечения может перейти в хроническую форму.
Стрептодермия
Инфицирование происходит контактно-бытовым путем через прямой контакт с больным человеком или через предметы обихода. Заболеванию больше подвержены дети дошкольного возраста, вспышки стрептодермии часто наблюдаются в детских садах.
Инкубационный период при стрептодермии составляет 7-10 дней, затем на коже появляются крупные розовые пятна с неровными краями, которые через несколько дней перерождаются в гнойно-пузырьковые элементы. Постепенно пузырьки лопаются, покрываются корочкой и проходят без следа. При тяжелой форме стрептодермии, когда воспалительный процесс затрагивает глубокие слои кожи, могут остаться шрамы. Среди других клинических проявлений при стрептодермии наблюдаются:
сухость и зуд кожи;
увеличение близлежащих лимфатических узлов;
небольшое повышение температуры тела (до 38 ºC);
легкое недомогание, слабость.
Первично стрептодермия поражает ограниченные участки кожи, но нарушение правил гигиены и отсутствие лечения приводят к тому, что воспалительный процесс распространяется на здоровые ткани.
Длительность заболевания напрямую зависит от качества и своевременности терапии, а также соблюдения врачебных рекомендаций по уходу за пораженной кожей.
Уретрит
Заражение чаще всего происходит во время полового контакта. Инкубационный период при уретрите составляет 5-30 дней. Основными симптомами бактериального уретрита являются:
болезненность при мочеиспускании;
гнойные выделения с неприятным запахом;
отечность половых органов;
возможно наличие крови в моче.
Общее состояние обычно остается нормальным, иногда больные жалуются на слабость, недомогание, отсутствие аппетита.
При отсутствии лечения инфекция может перейти в хроническую форму, проникнуть в мочевой пузырь и почки, что приведет к развитию цистита и нефрита. Запущенный хронический уретрит нередко становится причиной бесплодия у мужчин и женщин.
Диагностика
Ведущую роль в диагностике стрептококковых инфекций играют лабораторные методы исследования. При подозрении на стрептококк больным назначают:
бактериологическое исследование биоматериалов (налета с миндалин, отделяемого из половых органов, содержимого пузырьков на коже, крови) - используется для выделения и определения типа возбудителя;
серологическая диагностика (иммуноферментный анализ, метод цепной полимеразной реакции) - применяется для обнаружения в крови антител к возбудителю, выделяемым им токсинам.
Для оценки состояния внутренних органов дополнительно проводятся ультразвуковое исследование мочевого пузыря (УЗИ), рентгенография легких, электрокардиограмма, назначаются консультации отоларинголога, уролога, кардиолога и других специалистов.
Лечение
Лечение легких форм стрептококковых инфекций проводится в амбулаторных условиях, больные с тяжелыми формами госпитализируются в профильное отделение стационара. Основу лечения заболеваний, вызванных стрептококками, составляют антибактериальные препараты пенициллинового ряда.
Симптоматическое лечение зависит от клинической формы заболевания. Дополнительно больным назначаются жаропонижающие, противовоспалительные, антигистаминные препараты и витамины. При тяжелых состояниях проводятся внутривенные вливания водно-солевых растворов. Продолжительность курса лечения зависит от формы болезни и тяжести инфекционного процесса.
Осложнения
Стрептококковые инфекции могут приводить к развитию тяжелых осложнений и аутоиммунных нарушений - состояний, при которых организм принимает здоровые клетки за бактерии и начинает их атаковать. Наиболее частыми осложнениями стрептококковых инфекций становятся:
ревматизм - хроническое заболевание, протекающее с поражением суставов, мышц и сердечно-сосудистой системы;
хронический лимфаденит - воспаление лимфатических узлов;
гломерулонефрит - тяжелое заболевание почек, приводящие к развитию почечной недостаточности;
воспалительные заболевания сердца (перикардит, миокардит, эндокардит);
сепсис - общее заражение организма.
Обратите внимание! Особенно опасны стрептококковые инфекции в детском возрасте. Нередко родители не обращаются к врачу и лечат такие серьезные болезни, как ангина или скарлатина, самостоятельно. Этого нельзя делать ни в коем случае, поскольку вероятность развития ревматизма и бактериального эндокардита после перенесенной ангины и скарлатины очень высока!
Последствия
При своевременном обращении за медицинской помощью в большинстве случаев стрептококковые инфекции заканчиваются полным выздоровлением. Ухудшает прогноз поздно начатое лечение, переход заболевания в хроническую форму, а также ослабленный иммунитет у больного человека.
Профилактика
Профилактические меры при стрептококковой инфекции включают соблюдение правил личной гигиены и применение средств индивидуальной защиты (ношение маски, тщательная обработка посуды и поверхностей, на которые могли попасть микроорганизмы, мытье рук с мылом).
Общая профилактика заключается в осуществлении контроля над состоянием здоровья в детских и трудовых коллективах. Медработниками учреждений проводятся профилактические осмотры в школах и детских садах, выявляются скрытые формы носительства стрептококковой инфекции, обнаруженные носители изолируются и пролечиваются.
Предупреждение заражения родивших женщин и новорожденных состоит в строгом соблюдении санитарно-гигиенических норм и режима, разработанных для отделений гинекологии и родильных домов.
Питание
В острую фазу болезни помимо приема назначенных лекарственных препаратов следует придерживаться специальной диеты. Из ежедневного рациона необходимо исключить продукты с высоким содержанием углеводов: мучные изделия, шоколад, варенье, мороженое, отказаться от острой, маринованной и соленой пищи.
В рацион рекомендуется включить фрукты и овощи, каши, продукты, богатые белком, витаминами и минеральными веществами. Пищу следует готовить на пару, отваривать или запекать. При ангине блюда подаются в протертом виде. В период выраженной интоксикации больным назначается теплое обильное питье. Пищу принимать небольшими порциями по 5-6 раз в день. При нормализации состояния больным разрешается постепенно вернуться к привычному режиму питания.
Стрептококковая инфекция: диагностика и лечение
У каждого инфекционного заболевания есть возбудители — патогенные или условно-патогенные микроорганизмы. Первые вторгаются в организм извне, вторые принадлежат к малочисленной части естественной микрофлоры и активизируются только при благоприятных для размножения условиях.
Этиологию инфекции определяют по ее принадлежности к группе — вирусам, бактериям, протозойным микроорганизмам, грибкам, глистам или простейшим паразитам. Среди большого количества бактерий к категории особо опасных относятся стрептококки. Они провоцируют тяжелые патологии — вплоть до токсического шока с высокой вероятностью летального исхода. Об особенностях стрептококковой инфекции, методах лечения и профилактики расскажем в статье.
Источник инфекции — зараженный ребенок или взрослый. Пути передачи стрептококка:
- аэрогенный — во время близкого общения с больным человеком, включая бессимптомное носительство инфекции;
- пищевой — через зараженную еду — молочные, кисломолочные продукты;
- контактно-бытовой — через предметы, обсемененные бактериями;
- интранатальный — если половая система женщины поражена стрептококковой инфекцией.
Из-за высокой контагиозности возбудителей существует риск эпидемии среди социально-организованных детей.
Классификация стрептококков
Streptococcus — грамположительные бактерии факультативно-аэробного вида. В мизерном количестве они обитают на коже, в ЖКТ, на слизистых рта и органов мочеполовой системы. Бактериальное семейство насчитывает 83 представителя. Причинно-значимыми являются:
- A-гемолитический Streptococcus — вызывает гнойные инфекции, воспалительные патологии сердца, пневмококковую пневмонию.
- B-гемолитический Streptococcus — включает пять групп опасных возбудителей (A, B,C, D, F, G). Самым активным считается Streptococcus pyogenes группы А, провоцирующий болезни ЛОР-органов, дыхательной системы, острые воспаления сердца, почек, тяжело излечимые поражения кожи.
Бактерии достаточно устойчивы к факторам окружающей среды. Они выдерживают температуру до 60℃, в течение четверти часа способны противостоять антисептикам, санитайзерам. В засохшей мокроте, гное сохраняют жизнеспособность в течение нескольких месяцев.
Факторы вирулентности
Стрептококкам свойственна высокая вирулентность — способность быстро захватить и погубить атакованный организм. Основными факторами служат умения микроорганизмов:
- оперативно колонизироваться и диссеминировать;
- обходить иммунную защиту;
- мгновенно связываться со специфическими рецепторами для вхождения в клетки организма.
Патогены вырабатывают вещества, разрушающие ткани, а также экзотоксины, которые провоцируют развитие цитокинового шторма. Это главная причина токсического шока и летального исхода. Проникая через слизистые ротоглотки или повреждения на коже, возбудитель образует бактериально-активный очаг, в который включается и условно-патогенная микрофлора. Стрептококки выделяют в кровь ядовитые вещества, вызывающие системный иммунный ответ — выброс цитокинов, гистамина, синтез иммуноглобулинов. При значительной бактериальной нагрузке, ослабленном иммунитете организм не может дать возбудителю достойный отпор. Течение болезни может быть крайне тяжелым, лечение — длительным, а риск постинфекционных осложнений — высоким.
Болезни, вызываемые стрептококками
Активный β-гемолитический Streptococcus группы А вызывает болезни с разной симптоматикой и течением. Клиническая картина стрептококковой инфекции зависит от локализации воспалительного очага, бактериальной нагрузки, преморбидного фона пациента. Из-за «живучести» достаточно сложно подобрать эффективное лекарство от инфекционного заболевания.
Стрептококковый фарингит
Воспаление локализуется на задней стенке глотки — в слизистой оболочке. Инкубационный период длится 2-3 дня, затем появляются острые симптомы — боль при проглатывании слюны, увеличение и болезненность шейных лимфоузлов, гипертермия. Примерно у 20% пациентов в инфекционный процесс вовлекается лимфаденоидная ткань миндалин, развивается фаринготонзиллит. Болезнь характеризуется высокой температурой, образованием серозно-гнойных пробок на слизистой миндалин, нестерпимой болью в горле. Осложнением может стать паратонзиллярный абсцесс.
Скарлатина
Острое воспаление ротоглотки часто диагностируется у детей дошкольного возраста. Скарлатина дебютирует высокой температурой, признаками интоксикации организма. Характерные симптомы — отекший ярко-малиновый язык, мелкоточечные папулезные высыпания, локализующиеся преимущественно на лице и верхней части тела. При легких формах болезни разрешено амбулаторное лечение. Маленьких детей госпитализируют из-за риска гнойно-воспалительных осложнений.
Инфекции кожи
У детей часто встречается стрептодермия, у взрослых — рожистое воспаление или стрептококковая флегмона. Первые признаки стрептодермии — кожные фликтены, наполненные серозной жидкостью. Они трансформируются в гнойные пузырьки, после которых на коже образуются плотные корочки. Дети часто расчесывают зудящие высыпания, перенося стрептококк на здоровые участки кожного покрова, из-за чего лечение усложняется. Ускорить выздоровление помогает принудительное вскрытие фликтен с последующей обработкой кожи Фукорцином, антибактериальными мазями.
Рожистое воспаление — поверхностное воспаление кожи, флегмона — глубокое воспалительное поражение, распространяющееся на подкожно-жировую клетчатку. Заболевания сопряжены с головной болью, лихорадкой, бессонницей, регионарным лимфаденитом.
Некротизирующий фасциит
Гнойное воспаление соединительной ткани, сопряженное с отмиранием клеток кожи и подкожно-жирового слоя на пораженном участке. Характеризуется высокой скоростью развития, тяжестью течения, частыми осложнениями, рисками летальности. Патогенез тесно связан с тромбозом сосудов, из-за которого возникает дефицит кислорода, поступающего к мягким тканям.
Синдром токсического шока (СТШ)
Большая часть случаев СТШ связна с применением суперабсорбирующих гигиенических тампонов во время месячных. Крайне тяжелое соматическое состояние вызывается гиперцитокинемией — перепроизводством цитокинов в ответ на поражение организма токсинами стрептококков. Это приводит к разрыву информационных связей между Т-лимфоцитами, в результате чего они атакуют клетки собственного организма. Резко увеличивается проницаемость сосудов, падает давление, межклеточное пространство заполняется плазмой, развивается полиорганная недостаточность. Страдают легкие, сердце, затем отказывают почки, печень.
Поздние осложнения
Механизм развития поздних осложнений не изучен. К основным патологиям относятся гломерулонефрит, сепсис, некротический миозит, ревматическая лихорадка.
Идентифицировать возбудителя активной формы болезни или выявить носительство инфекции можно с помощью лабораторных исследований биоматериала (соскоба с кожи, мазка из горла). Для диагностики применяют бактериологический посев. При обнаружении колоний стрептококка дополнительно выполняют антибиотикограмму — определение резистентности к разным видам антибиотиков.
Препараты для этиотропной терапии детям и взрослым подбирают по результатам лабораторной диагностики. Многие бактерии гемолитического стрептококка проявляют чувствительность к антибиотикам пенициллиновой группы. При неэффективности лечения пенициллины заменяют макролидами — Сумамедом, Азитромицином, Кларитромицином. Для предотвращения дисбаланса микрофлоры параллельно назначают пробиотики и пребиотики. Дополнительно проводят лечение симптомов исходя из клинической картины заболевания. Из современных препаратов рекомендуется использовать Бактериофаг стрептококковый — раствор для орошений слизистых, аппликаций, клизм, спринцевания.
Стрептококки: чем опасны, как выявлять и лечить

Род бактерий, относящихся к условно патогенной микрофлоре. Носителями различных стрептококков являются практически все люди, включая младенцев. В норме активность микробов подавляет иммунитет. При ослаблении его защиты или получении извне большой заражающей дозы развиваются стрептококковые инфекции: воспалительные заболевания, поражающие слизистые дыхательных путей, ткани внутренних органов, зубы или оболочки мозга. Стрептококки очень устойчивы к факторам внешней среды, способны вырабатывать резистентность к антибактериальным препаратам.
Что такое стрептококки
Род Streptococcus объединяет разнообразные грамположительные микроорганизмы, способные размножаться в анаэробных условиях. Бактерии имеют шаровидную форму, их оболочки чрезвычайно устойчивы к агрессии внешней среды. В высушенных образцах биологических материалов стрептококки сохраняются жизнеспособными более года. Погибают при кипячении, химические дезинфицирующие препараты убивают их в течение 20 минут. По этой причине поверхностного антисептирования часто бывает недостаточно.
Источник распространения стрептококков — носители: зараженные или больные люди. В большой концентрации инфекция содержится на поверхности слизистых оболочек, в жидкостных выделениях: гное, экссудате, слюне. Микробы передаются от человека к человеку воздушно-капельным путем при чихании или кашле. В отличие от вирусов стрептококки разлетаются на относительно небольшое расстояние от источника: в радиусе не более трех метров. Высокая устойчивость бактерий во внешней среде определяет также алиментарный путь заражения: через грязные руки, продукты питания. Стрептококки длительное время сохраняются в молоке, мясных и морепродуктах, которые являются для этой группы инфекций питательную среду.
При размножении в организме человека стрептококки провоцируют интенсивные воспалительные реакции:
микробы группы А чаще поражают слизистые носа, ротовой полости, гортани, бронхов и легких, слухового аппарата, кожи, становятся возбудителями синуситов, тонзиллита, кариеса, ангины, пневмонии, дерматитов, рожи, скарлатины, осложнения ран и ожогов;
стрептококки группы В обычно провоцируют воспаления тканей мочевыделительной системы, суставных структур, соединительной ткани, вызывают цистит, адрекситы, инфекционные нефриты, ревматические процессы, послеродовые осложнения у женщин, эти микробы могут передаваться при половых контактах.
Развитию стрептококковых инфекций способствуют различные системные патологии и повреждения тканей. В том числе: сахарный диабет, злокачественные опухоли, иммунодефицитные, послеоперационные состояния, гиповитаминозы, открытые раны.
Признаки инфицирования
Распространенные симптомы стрептококковых инфекций:
повышение местной или общей температуры тела;
зуд, жжение, сухость в области гортани;
отечность и покраснение миндалин, образование желтого или сероватого налета на слизистых;
заложенность носа с последующими густыми выделениями зеленоватого или желтого цвета;
резкая боль и заложенность слухового прохода, серозные выделения с примесью гноя.
У большинства людей природная высокая склонность к заражению стрептококками. При передаче того или иного вида инфекции воспаляются так называемые входные ворота. Возникают ларингит, фарингит, ангина, отит. При распространении микробов из очагов заражения страдают нижние дыхательные пути, мозг, почки, кишечник и другие органы. К инфекциям вторичной формы можно отнести процессы с включением аутоиммунных механизмов: ревматоидный артрит, стрептококковый васкулит, гломерулонефрит.
Стрептококки — частые провокаторы токсических и некротических осложнений, в том числе тяжелой лихорадки, абсцессов и сепсиса.
Диагностика и лечение стрептококковых инфекций
Специфическая диагностика патогенов требует проведения бактериологического анализа соскобов слизистых, образцов слюны, мочи, мокроты, гнойного отделяемого и других биоматериалов. Кроме того, часто бывает необходимо тестирование крови на антитела к стрептококкам. Лабораторные исследования устанавливают вид возбудителя болезни в течение 20-30 минут.
Кроме этиологических анализов при различных патологиях требуется диагностика общего состояния поражениях органов: обследование у отоларинголога, проведение УЗИ, флюорографии и некоторых других.
Тактику лечения подбирают с учетом выявленных нарушений и устойчивости микробов к медикаментам. Терапию проводят врачи различных профилей: гинекологи, терапевты, пульмонологи, дерматологи. Для подавления активности инфекционной микрофлоры больным назначают курс антибиотиков. Против стрептококков эффективны Азитромицин, Эритромицин,препараты из ряда фторхинолонов: Ципрофлоксацин, Левофлоксацин. Покупать и применять медикаменты важно по назначению врача. Самодеятельность в этом вопросе приводит к развитию суперинфекций. Терапию дополняют также иммуномодулирующими средствами.
Предотвратить развитие стрептококковых заболеваний помогают санитарные меры, закаливание, использование антисептических средств.
Анализ на антистрептолизин - показания, нормы, расшифровка результата теста на АСЛ-О

Выпускник медицинского факультета УЛГУ. Интересы: современные медицинские технологии, открытия в области медицины, перспективы развития медицины в России и за рубежом.
- Запись опубликована: 07.03.2022
- Reading time: 3 минут чтения
Заболевания, вызванные стрептококками, могут протекать бессимптомно, и при отсутствии лечения давать тяжелые осложнения. Поэтому очень важно своевременно обнаружить инфекцию, сделать это можно лабораторным путем. Заражение стрептококками группы А запускает выработку антител против этих бактерий. Подтвердить их наличие возможно по результатам анализа на антистрептолизин (ASO, АСЛО). АСLО можно определить через 4-6 недель после заражения.
Что такое стрептолизин и антистрептолизин?
Стрептолизин — специфический токсин, продуцируемый бактериями из стрептококковой группы, играющий важную роль в патогенезе заболевания и в развитии иммунного ответа зараженного организма. Экзотоксины и ферменты стрептококков группы A (стрептолизин S и О) оказывают местное и системное токсическое действие, способствуя появлению ряда симптомов и распространению инфекции. Они повреждают клеточные мембраны и вызывают гемолиз (разрушение эритроцитов), а также другие опасные реакции. Пример действия эритрогенного токсина — характерная сыпь при скарлатине
В ответ на выработку стрептолизина, организм производит антитела — антистрептолизин, борющиеся с инфекцией. Уровень антистрептозилиновых антител повышается через неделю после заражения. Максимальная концентрация достигается между 4-6 неделями. Затем уровень антител постепенно снижается, но антистрептолизин может быть обнаружен в организме и через несколько месяцев после заболевания.
На этой реакции основан анализ на АСЛ-О. Антистрептолизиновая реакция, представляет собой тест, выполняемый для обнаружения в плазме антител, направленных против стрептолизина O. Анализ показывает, была ли у пациента стрептококковая инфекция и является ли больной ее носителем. Тест на АСLО не используется для выявления острых инфекций, так как вначале заболевания антител ещё нет.
Когда назначается анализ на антистрептолизин?
Определение АСО проводится у больных с подозрением на осложнения после предшествующей инфекции, особенно если пациент ранее не сдавал анализ на бактериальную культуру. Анализ позволяет выявить зараженных пациентов, даже если симптомы заболевания были скудными и неспецифическими. Тест на антистрептолизин также полезен для мониторинга эффектов лечения антибиотиками во время течения заболевания.
Учитывая, что осложнения после нелеченных стрептококковых инфекций очень опасные и приводят к сердечной недостаточности, повышенный уровень АСО — ценный параметр, позволяющий обнаружить наличие бактерий и применить соответствующее лечение.
Чем опасны стрептококки?
Стрептококки в первую очередь атакуют дыхательную систему, особенно горло и верхние дыхательные пути. Также стрептококковые инфекции провоцируют воспаление уха, носовых пазух и суставов. Бывает, что заболевание дает мало симптомов и остается нелеченым. В таких случаях бактерии распространяются внутри организма, приводя к осложнениям — гломерулонефриту, ревматической лихорадке, повреждению сердечных клапанов и суставов.
При этом, если инфекцию выявить, она вполне излечима — способ борьбы заключается в использовании соответствующего антибиотика. Поэтому при подозрении на стрептококковую инфекцию, следует незамедлительно сдать анализ на антистрептолизин, что позволит подобрать правильную стратегию лечения.
Симптомы, указывающие на гломерулонефрит:
- уменьшение количества выделяемой мочи; ; ;
- снижение концентрации внимания; ;
- миалгия — боль в мышцах; ;
- возможна сыпь.
Симптомы ревматической лихорадки:
- повышение температуры тела;
- отеки;
- боль;
- покраснение области суставов;
- непроизвольные движения - хорея Сиденгама;
- образование многочисленных подкожных узелков и высыпаний;
- миокардит, проявляющийся быстрым или неравномерным сердцебиением;
- одышка;
- возможна боль в груди.
При таких симптомах необходимо срочно обратиться к врачу и обследоваться.
Тест ASO - подготовка и выполнение анализа
Предварительная подготовка к анализу на антистрептолизин не требуется. Кровь можно сдавать не натощак. Но чтобы результат теста был надежным, его необходимо повторить через две недели.
Нормы АСЛ-О
У здоровых людей антитела к стрептолизину в крови должны отсутствовать. Однако из-за распространенности стрептококков у большинства пациентов они обнаруживаются в умеренных количествах.
Таблица 1. Нормы АСЛ-О у взрослых и детей
| Возраст | Нормы антистрептолизина |
| Взрослые | 200 МЕ/мл |
| Дети | 333 МЕ/мл |
Важно понимать, что каждая диагностическая лаборатория имеет свои референсные диапазоны. Они указываются в бланке анализа, и именно с ними следует сравнивать полученные результаты.
Расшифровка анализа АСЛ О: повышенный и пониженный антистрептолизин
Повышенный результат АСО указывает на недавнюю или продолжающуюся стрептококковую инфекцию. При таком результате важно повторить анализ, чтобы проследить направление заболевания.
- Если при следующем тесте уровень антител снижается, это означает, что инфекция правильно лечится.
- Если титр антител стал выше, это признак того, что бактериальная инфекция все еще развивается. В этом случае требуется назначение антибиотика, например, амоксициллина, который затормозит развитие заболевания.
Значительно повышается АСЛ-О в ходе ревматической лихорадки (частого осложнения стрептококковой ангины), гломерулонефрита, эндокардита, скарлатины, фарингита, пневмонии, стенокардии и токсического шока.
Важно понимать, что анализ на антистрептолизин не отражает риск осложнений или тяжесть заболевания. Он всего лишь показывает антистрептолизиновую реакцию. Поэтому, если уровень АСО повышен, но не сопровождается симптомами инфекции, и титр антител со временем не меняется, то лечение не требуется.
Пациент может быть только носителем стрептококковой инфекции. Отсутствие активной инфекции можно подтвердить, выполнив общий анализ крови или анализ на СОЭ.
Очень низкий титр антител или отрицательный тест ASO обычно означает, что в последнее время в организме не было стрептококковой инфекции. Результат можно подтвердить повторным тестом с отрицательными антителами.
При интерпретации результата анализа на антистрептолизин также важно учитывать, что 20% людей вообще не вырабатывают антистрептолизиновые антитела, а у 5% пациентов их уровень может быть постоянно повышен, без связи с течением инфекции.
Читайте также:
